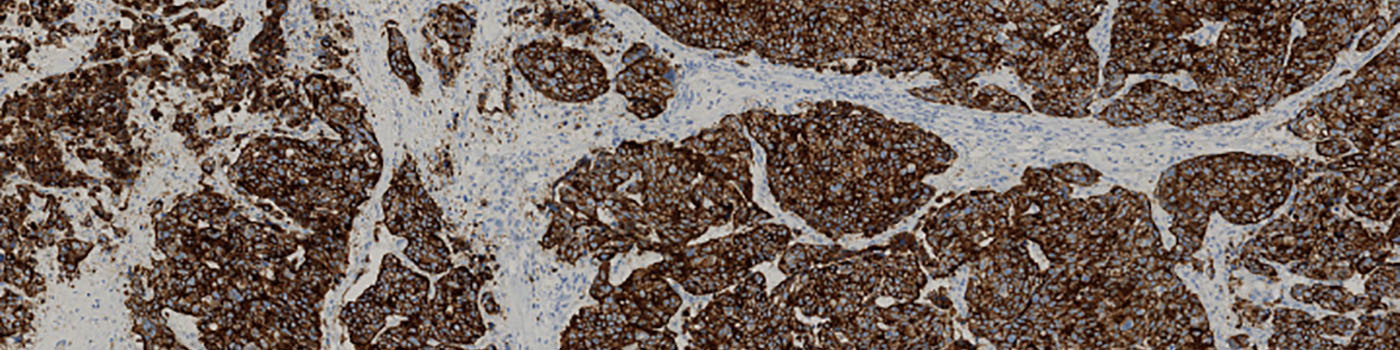
CK8/18, Breast Cancer

Field of view showing invasive tumor in an image of a TMA core of breast tissue stained by IHC for CK. The core ROI has been outlined automatically (green hatched line).

#10047
Cytokeratins (CKs) are intermediate filament proteins located in the cytoplasm. CKs belong to the most fundamental markers of epithelial differentiation; including that of the epithelia of breast ductal carcinoma, see [1].
This APP can be used to determine the tumor density i.e. the area of tumor growth compared to tissue area. With some precaution, the tumor region can be defined as the region where certain CKs are expressed in the cytoplasm.
NOTE: To get an optimal and unbiased result, the APP is dependent on a stable staining intensity.
Quantitative Output variables
The output variables obtained from this protocol include:
Methods
Two color deconvolution bands are used as preprocessing steps to enhance tissue and tumor regions. These color bands are filtered with a median filter to smoothen the image while preserving the edges.
The classification of the tumor and non-tumor region is based on an intensity based thresholding classifier. The classifier segments the tissue into three parts: tumor, non-tumor and background corresponding to blue-, green- and clear-label, respectively.
The last processing step is the post-processing. Here the tumor-, non-tumor and clear-labels are expanded, thereby closing any clear-holes in the tumor- and non-tumor labels (See FIGURE 2 and 3).
Keywords
Breast ductal carcinoma, cytokeratin, tumor density, cytoplasmatic staining, cytoplasmatic intensity, quantitative, digital pathology, image analysis.
References
USERS
This APP was developed in cooperation with Professor Mogens Vyberg from NordiQC and Aalborg University Hospital.
LITERATURE
1. NordiQC: Pan Cytokeratin. (Last updated/Accessed: 23-08-2019).